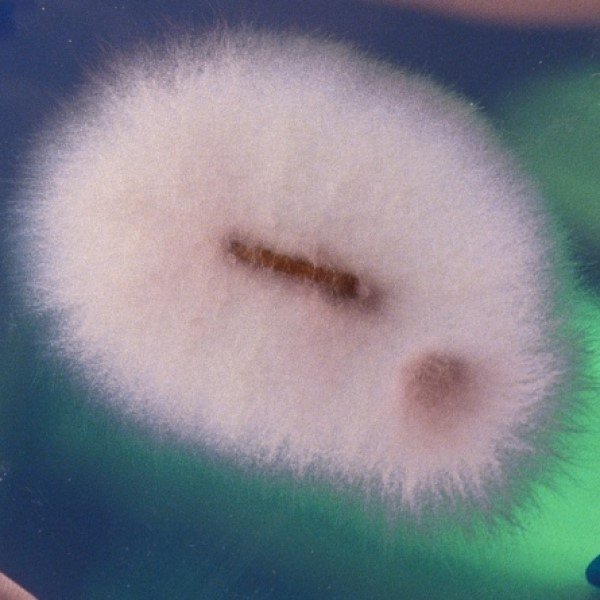
Explorando Micropadrões de Plantas e Fungos

A natureza é, sem dúvida, a artista mais prolífica e sofisticada que jamais existiu. Enquanto admiramos paisagens grandiosas e flores exuberantes, um universo de beleza extraordinária permanece oculto aos nossos olhos desarmados. Os micropadrões presentes em plantas e fungos revelam uma dimensão estética que desafia nossa percepção convencional de arte, apresentando geometrias complexas, texturas fascinantes e composições cromáticas que rivalizam com as obras dos grandes mestres da pintura abstrata.
A microtopografia artística emerge como uma categoria que celebra essas manifestações invisíveis da beleza natural. Trata-se de uma exploração visual que nos convida a mergulhar nas estruturas microscópicas da vida vegetal e fúngica, onde cada célula, cada espora e cada tricoma se revela como uma obra-prima em miniatura. Através de lentes de aumento, microscópios e técnicas fotográficas especializadas, podemos finalmente testemunhar a maestria arquitetônica que a evolução esculpiu ao longo de milhões de anos.
A Geometria Secreta das Estruturas de Plantas e Fungos
As plantas desenvolveram padrões microscópicos de complexidade impressionante, cada um cumprindo funções específicas de sobrevivência enquanto exibe uma estética surpreendente. As células epidérmicas, por exemplo, formam mosaicos tridimensionais que lembram instalações de arte contemporânea. Sob magnificação, a superfície de uma folha comum se transforma em uma paisagem alienígena, onde células em formato de quebra-cabeças se encaixam perfeitamente, criando padrões que parecem ter sido desenhados por um designer gráfico visionário.
Os estômatos, pequenas aberturas responsáveis pelas trocas gasosas, distribuem-se pela superfície foliar seguindo padrões matemáticos precisos. Essas estruturas reniformes, cercadas por células-guarda que se abrem e fecham em resposta a estímulos ambientais, criam composições que evocam o pontilhismo de Seurat ou os padrões repetitivos da arte islâmica. A densidade, distribuição e orientação dos estômatos variam entre espécies, gerando assinaturas visuais únicas que funcionam como impressões digitais botânicas.
Tricomas: Esculturas Microscópicas em Três Dimensões
Os tricomas são estruturas pilosas que emergem da epiderme das plantas, assumindo formas extraordinariamente diversas. Alguns são simples pelos unicelulares, enquanto outros se ramificam em estruturas arbóreas complexas, formando verdadeiras florestas em miniatura sobre a superfície foliar. Existem tricomas glandulares repletos de óleos essenciais, tricomas estrelados com múltiplos braços radiantes e tricomas escamiformes que se sobrepõem como telhas de um telhado microscópico.
Como observou a botânica e artista visual Anna Atkins em seu trabalho pioneiro com cianótipos no século XIX: “A natureza apresenta uma infinidade de formas que superam qualquer imaginação humana, e cada detalhe revela a mão de um artista supremo” (Atkins, A. “Photographs of British Algae: Cyanotype Impressions”, 1843).
Essa percepção permanece verdadeira quando ampliamos nossa visão para o mundo microscópico, onde os tricomas se revelam como esculturas abstratas de uma beleza intrigante.
Padrões de Venação: Mapas Fractais de Plantas e Fungos
A arquitetura vascular das plantas constitui um dos sistemas de padrões mais fascinantes da natureza. As nervuras foliares ramificam-se em hierarquias fractais, onde cada subdivisão replica a estrutura maior em escala reduzida. Esse design não apenas otimiza o transporte de água e nutrientes, mas cria composições visuais de elegância matemática. Sob luz transmitida, as folhas se transformam em vitrais naturais, com a rede vascular desenhando mapas orgânicos que lembram sistemas fluviais vistos do espaço.
Diferentes grupos de plantas desenvolveram padrões de venação característicos. As dicotiledôneas frequentemente exibem venação reticulada, com nervuras secundárias formando redes complexas que parecem teias elaboradas. As monocotiledôneas, por outro lado, apresentam nervuras paralelas que criam padrões de linhas rítmicas, evocando obras minimalistas contemporâneas. Algumas espécies tropicais desenvolveram padrões de venação tão complexos e belos que suas folhas são colecionadas como objetos artísticos naturais.
O Universo Cromático dos Fungos Microscópicos

Os fungos, frequentemente negligenciados em discussões sobre beleza natural, revelam uma paleta cromática surpreendente quando observados em detalhes microscópicos. Esporos fúngicos exibem colorações que variam do branco puro ao negro profundo, passando por amarelos vibrantes, vermelhos intensos, azuis elétricos e verdes iridescentes. Essas cores não são meramente ornamentais; elas resultam de compostos químicos complexos que protegem os esporos da radiação ultravioleta e auxiliam na dispersão.
A diversidade morfológica dos esporos é igualmente impressionante. Alguns são perfeitamente esféricos, como pequenas pérolas microscópicas. Outros apresentam formas elipsoidais, cilíndricas ou fusiformes. Existem esporos com ornamentações elaboradas: verrugas, espinhos, cristas, reticulações e apêndices que lhes conferem aparência de joias minúsculas ou naves espaciais alienígenas. Sob microscopia eletrônica de varredura, essas estruturas revelam texturas e detalhes que desafiam descrição verbal.
Hifas: Tecelagens de Plantas e Fungos em Escala Nano
O micélio, a massa de filamentos que constitui o corpo vegetativo dos fungos, forma padrões de crescimento hipnotizantes. As hifas, filamentos tubulares individuais, entrelaçam-se em redes tridimensionais de complexidade extraordinária. Essas estruturas crescem seguindo gradientes químicos e físicos, criando padrões ramificados que lembram simultaneamente redes neurais, sistemas radiculares e galáxias fractais.
Alguns fungos produzem estruturas especializadas particularmente belas. Os basídios, células produtoras de esporos em cogumelos, organizam-se em paliçadas ordenadas nas lamelas, formando padrões geométricos precisos. As ascos, estruturas equivalentes em outro grupo fúngico, assemelham-se a pequenos sacos translúcidos alinhados em fileiras, criando texturas que evocam tecidos microscópicos. A regularidade dessas formações contrasta com a aparente aleatoriedade do crescimento micelial, demonstrando a capacidade da natureza de equilibrar ordem e caos.
Liquens: Simbiose Artística em Miniatura
Os liquens representam uma fascinante colaboração entre fungos e algas ou cianobactérias, e suas estruturas microscópicas refletem essa parceria simbiótica. A superfície de um líquen, quando magnificada, revela um mosaico complexo onde células fotossintéticas verdes ou azuis-esverdeadas encontram-se envolvidas por hifas fúngicas protetoras. Essa arquitetura simbiótica cria padrões únicos que variam enormemente entre espécies.
Alguns liquens desenvolvem estruturas reprodutivas chamadas sorédios e isídios, que se projetam da superfície como pequenas esculturas. Os sorédios são agregados de células envolvidos por hifas, enquanto os isídios são projeções cilíndricas ou coraloides. Sob magnificação, essas estruturas revelam-se como jardins microscópicos, com formas que lembram corais, cogumelos em miniatura ou estruturas cristalinas. A diversidade morfológica dos liquens oferece um campo virtualmente inesgotável para exploração visual.
Técnicas de Visualização e Captura de Plantas e Fungos
A documentação artística dos micropadrões de plantas e fungos requer técnicas especializadas que combinam conhecimento científico e sensibilidade estética. A microscopia óptica tradicional permanece fundamental, permitindo observações com aumentos de até mil vezes. Técnicas de iluminação criativa, como campo claro, campo escuro, contraste de fase e luz polarizada, revelam diferentes aspectos das estruturas microscópicas, cada uma criando efeitos visuais distintos.
As principais técnicas de visualização incluem:
- Microscopia de fluorescência: utiliza corantes fluorescentes para destacar estruturas específicas, criando imagens vibrantes com cores intensas contra fundos escuros
- Microscopia eletrônica de varredura (MEV): produz imagens tridimensionais de alta resolução, revelando detalhes de superfície com profundidade dramática
- Microscopia confocal: permite a criação de seções ópticas que podem ser reconstruídas em modelos tridimensionais
- Fotografia macro com empilhamento de foco: combina múltiplas imagens em diferentes planos focais para criar composições com profundidade de campo impossível de obter em única exposição
- Microtomografia computadorizada: gera modelos 3D completos de estruturas microscópicas sem necessidade de destruir a amostra
A Interseção entre Ciência e Arte Visual

O estudo dos micropadrões de plantas e fungos situa-se em uma zona fascinante onde ciência e arte convergem naturalmente. Pesquisadores que documentam essas estruturas para fins científicos frequentemente produzem imagens de beleza extraordinária, enquanto artistas visuais interessados nesses padrões acabam contribuindo para o conhecimento científico através de suas observações detalhadas.
Como expressou o micologista e fotógrafo científico Martin Oeggerli: “Quando observamos o mundo microscópico com atenção, descobrimos que a fronteira entre ciência e arte se dissolve completamente. Cada imagem é simultaneamente um documento científico e uma obra de arte” (Oeggerli, M. “Micronaut: The Secret World of Microscopic Life”, 2017).
Essa perspectiva integradora enriquece ambos os campos, sugerindo que a separação artificial entre investigação científica e expressão artística limita nossa compreensão tanto da natureza quanto da criatividade humana.
Aplicações Contemporâneas em Design e Arquitetura
Os micropadrões de plantas e fungos têm inspirado designers, arquitetos e artistas contemporâneos a incorporar essas formas orgânicas em suas criações. A biomimética, campo que estuda soluções naturais para aplicação em design humano, frequentemente recorre a essas estruturas microscópicas como fonte de inovação. Padrões de venação foliar inspiram redes de distribuição eficientes, enquanto a arquitetura micelial informa projetos de estruturas leves e resistentes.
Artistas têxteis reproduzem padrões de células epidérmicas em tecelagens complexas. Designers gráficos incorporam geometrias estomáticas em identidades visuais. Arquitetos projetam fachadas baseadas na ramificação fractal de hifas fúngicas. Joalheiros criam peças inspiradas na morfologia de esporos ornamentados. Essas aplicações demonstram que a exploração estética do microscópico não é meramente contemplativa, mas pode gerar soluções criativas tangíveis em diversos campos.
Preservação e Documentação como Práticas Artísticas
A documentação fotográfica de micropadrões vegetais e fúngicos constitui uma prática artística legítima, comparável à fotografia de paisagem ou ao retrato. Fotógrafos especializados desenvolvem estilos visuais distintos, escolhendo espécies específicas, técnicas de preparação de amostras, métodos de iluminação e abordagens de pós-processamento que refletem suas visões artísticas individuais.
Alguns preferem a objetividade científica, apresentando as estruturas com máxima clareza e mínima manipulação. Outros adotam abordagens mais interpretativas, usando colorização artificial, composições abstratas e manipulação digital para criar obras que transcendem a mera documentação.
Coleções de preparações microscópicas históricas, mantidas em museus e universidades, constituem arquivos de beleza negligenciada. As lâminas preparadas por botânicos e micólogos ao longo de séculos contêm não apenas informação científica, mas também valor estético considerável. Iniciativas contemporâneas de digitalização dessas coleções tornam esse patrimônio visual acessível a públicos mais amplos, permitindo que artistas, designers e entusiastas explorem esse acervo de padrões naturais.
Gostou de aprender a Explorar os Micropadrões de Plantas e Fungos?
A microtopografia artística nos convida a reconsiderar nossa relação com a natureza e a expandir nossa definição de beleza. Ao dirigir nossa atenção para as estruturas microscópicas de plantas e fungos, descobrimos que a arte natural não se limita às manifestações macroscópicas que tradicionalmente celebramos. Cada organismo, por mais humilde que pareça, carrega em suas estruturas celulares um universo de padrões, formas e cores que rivalizam com qualquer criação humana.
Leia também: Texturas microscópicas em materiais orgânicos
Essa exploração também nos ensina humildade. A complexidade estética do microscópico desenvolveu-se ao longo de milhões de anos de evolução, refinada por incontáveis gerações e pressões seletivas. Os padrões que admiramos não são arbitrários ou meramente decorativos; cada elemento cumpre funções específicas de sobrevivência, demonstrando que eficiência funcional e beleza estética não são mutuamente exclusivas.
Ao contrário, a natureza nos mostra repetidamente que as soluções mais elegantes para problemas complexos frequentemente resultam em formas de beleza extraordinária. Que essa jornada pelos micropadrões de plantas e fungos inspire você a observar o mundo natural com renovada curiosidade, lembrando que a arte mais antiga e sofisticada está sempre ao nosso redor, aguardando apenas que ajustemos nossa percepção para apreciá-la plenamente.
